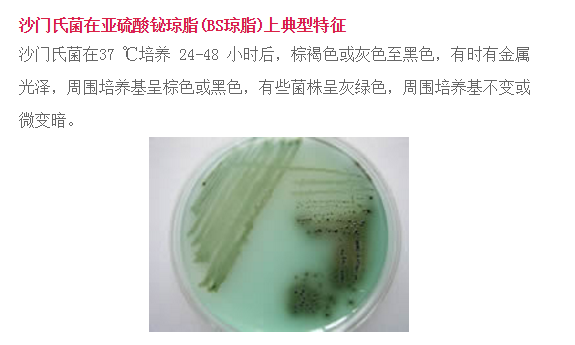
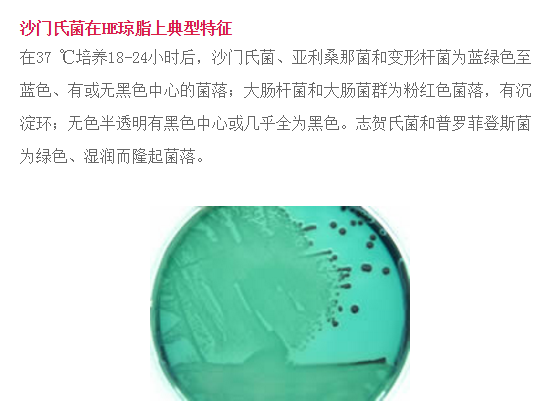
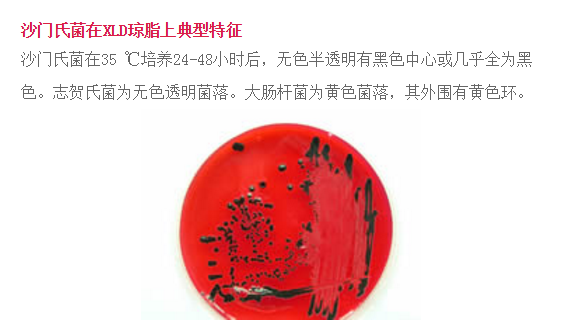
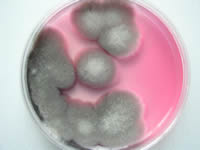

菌粉们,看到这里是不是叹为观止了,不要挪步,后面还有呢!
1、单增李斯特氏菌
单增李斯特氏菌在海博李斯特氏菌显色培养基上典型特征:
单增李斯特氏菌37 ℃培养24-28 小时,平板上出现蓝色菌落,菌落周围有一不透明环。绵羊李斯特氏菌37 ℃培养48小时 ,平板上出现蓝色菌落,菌落周围有一不透明环。西尔李斯特氏菌37 ℃培养24-48小时,平板上出现蓝色菌落,菌落周围没有不透明环。在食品检测中绵羊李斯特氏菌非常少见。

单增李斯特氏菌在PALCAM 琼脂平板上典型特征:李斯特氏菌在35 ℃培养24-48小时后,典型菌落在PALCAM 琼脂平板上为小的圆形灰绿色菌落,周围有棕黑色水解圈,有些菌落有黑色凹陷

2、酵母菌
酵母菌在孟加拉红培养基上典型特征:酵母菌在孟加拉红培养基上典型特征为红色菌落 。

酵母菌在马铃薯葡萄糖琼脂上典型特征:酵母菌在马铃薯葡萄糖琼脂上在28 ℃培养48小时后,乳白色菌落,有突起。

3、副溶血弧菌
副溶血性弧菌在TCBS培养基上典型特征:典型霍乱弧菌菌落为黄色,扁平,真径2-3mm ;副溶血弧菌菌落呈圆形 ,边缘整齐、湿润、稍混浊、半透明,多数具尖心、斗笠状,蓝绿色菌落,直径2-4mm 。

4、霉菌
霉菌在孟加拉红培养基上典型特征:霉菌在孟加拉红培养基上典型特征为灰色菌落,有黑色孢子 。
值得注意的是,如果细菌菌体接种于半固体培养基中或液体培养基中,是不能形成菌落的。在半固体培养基中,接种的无鞭毛的细菌只沿着穿刺线生长,而有鞭毛的细菌可在穿刺线的周围扩散生长。细菌菌体接种于液体培养基中,细菌生长后能使液体培养基变得混浊。混浊情况视细菌对氧气需求的不 同而有所不 同:好氧菌仅使上部培养液混浊,厌氧菌使底部培养液混浊,兼性厌氧菌使培养液上下均匀混浊;有的细菌可在培养液表面形成菌环或菌膜,或在底部产生沉淀。















 当前所在页面:
当前所在页面:



















